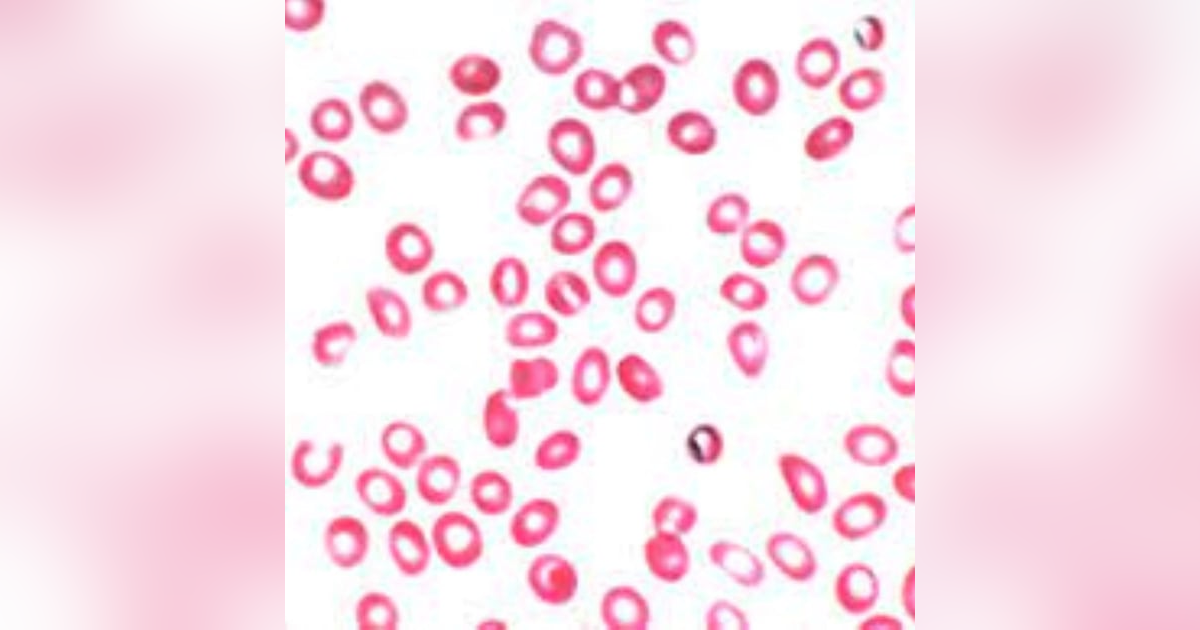

Dec. 23, 2021
S3 E2: More Than You Ever Wanted to Know: Microcytic Hypochromic Anemia: The Christmas Episode
Happy Holidays, everyone! This Christmas episode is a tad short, but I'm sure you have better things to do than listen to the history of disease.
In this episode, I'll address a famous person who possibly had this disease, the effect it had on him,...
Happy Holidays, everyone! This Christmas episode is a tad short, but I'm sure you have better things to do than listen to the history of disease.
In this episode, I'll address a famous person who possibly had this disease, the effect it had on him, and how he overcame it.
More Than You Ever Wanted to Know: Microcytic Hypochromic Anemia: The Christmas Episode
Show Notes:
https://www.ncbi.nlm.nih.gov/books/NBK470252/
Seuss. How The Grinch Stole Christmas. 1st ed.; 1957.
Podcast Promos:
Murder Incorporated @Murderincpod
Seriously Mysterious at Seriouslymysterious.com
In this episode, I'll address a famous person who possibly had this disease, the effect it had on him, and how he overcame it.
More Than You Ever Wanted to Know: Microcytic Hypochromic Anemia: The Christmas Episode
Show Notes:
https://www.ncbi.nlm.nih.gov/books/NBK470252/
Seuss. How The Grinch Stole Christmas. 1st ed.; 1957.
Podcast Promos:
Murder Incorporated @Murderincpod
Seriously Mysterious at Seriouslymysterious.com















